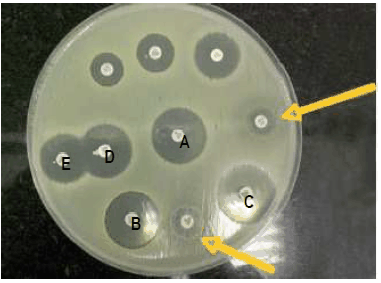
Enunciado 3227541-1

Considere a figura, que representa um teste de suscetibilidade de uma cepa de Staphylococcus aureus frente à fármacos antimicrobianos. Dadas as afirmativas, marque a correta.

Provas
Questão presente nas seguintes provas
Considere a figura, que representa um teste de suscetibilidade de uma cepa de Staphylococcus aureus frente à fármacos antimicrobianos. Dadas as afirmativas, marque a correta.